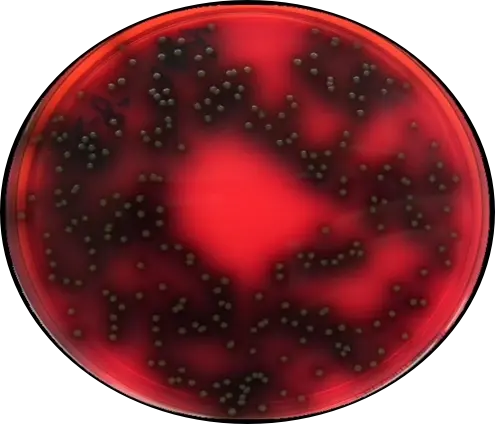
PALCAM琼脂（李斯特氏菌传统分离培养基）
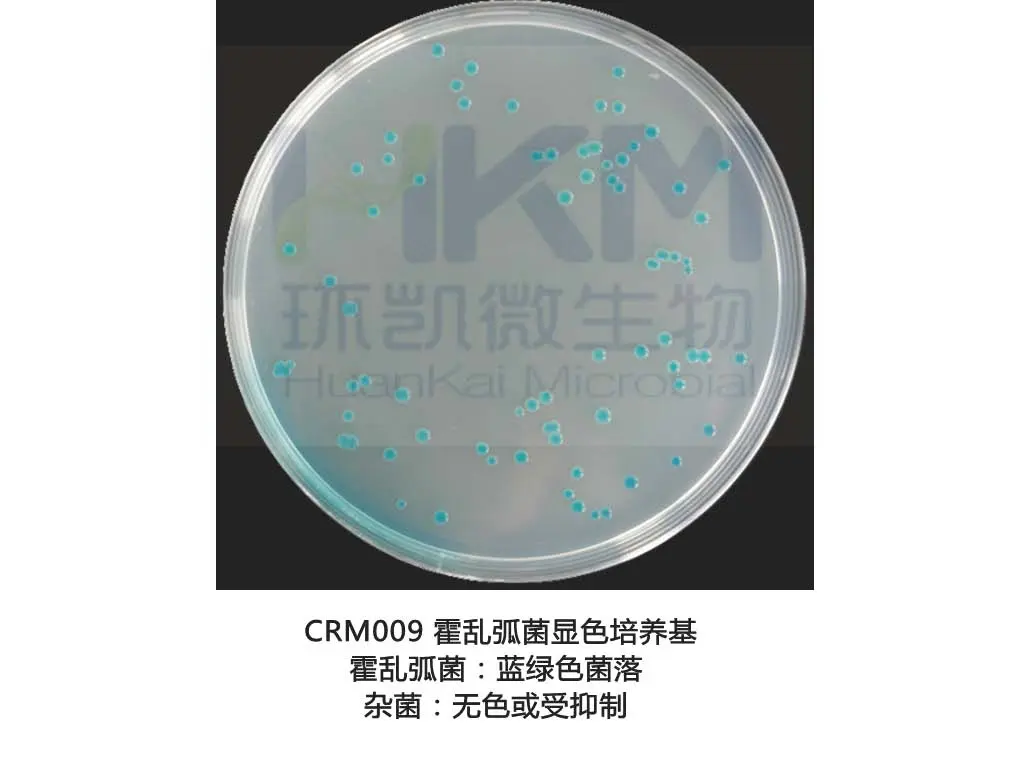
霍乱弧菌显色培养基
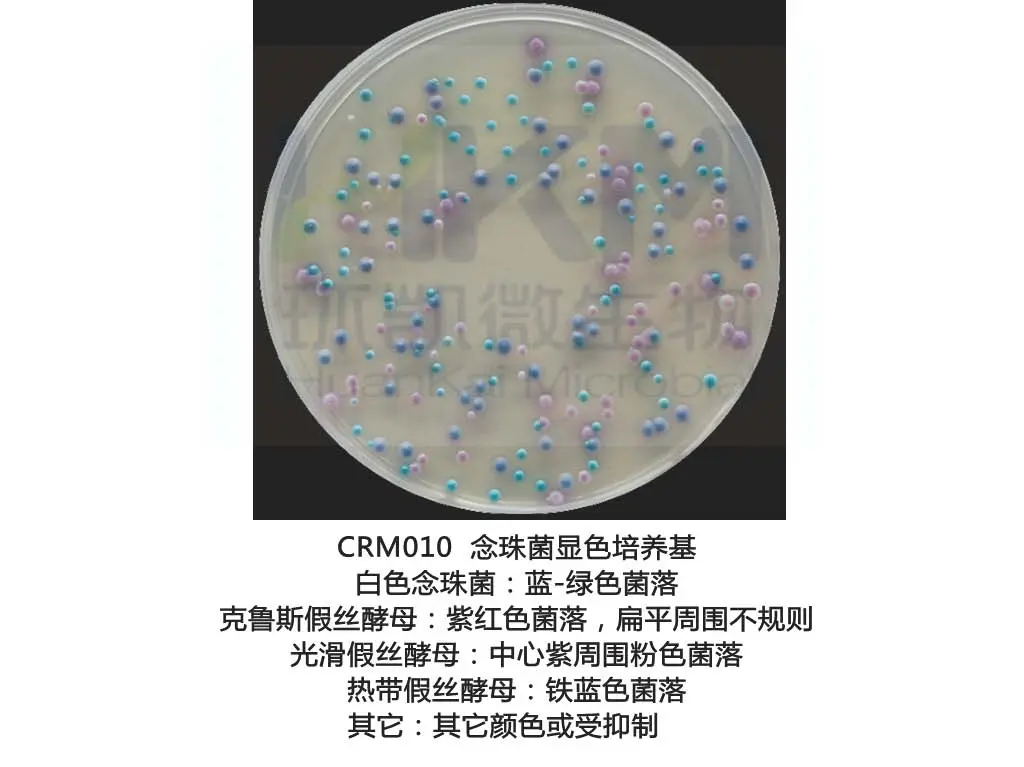
念珠苗显色培养基

显色培养基,您了解吗?— 简单出色快速出结果
发布时间:2023-09-04 浏览次数:2482
显色培养基是一类利用微生物自身代谢产生的酶与相应显色底物反应显色的原理来检测微生物的新型培养基。这些相应的显色底物是由产色基团和微生物部分可代谢物质组成,在特异性酶作用下,游离出产色基团显示一定颜色,直接观察菌落颜色即可对菌株作出鉴定。

相对于通过利用微生物自身代谢培养基中某种糖、氨基酸使培养基pH变化通过酸碱指示剂变色或代谢产物与培养基某些成分发生化学反应变色(如,产硫化氢沙门在XLD上形成黑色菌落)的传统分离鉴别培养基来说,它就是一种新型分离培养基,其反应的灵敏度和特异性大大优于传统分离鉴别培养基。假阳性率低,减少后续生化鉴定工作量,节约时间、原材料和资金投入,且最快24小时内出结果。

| 如:单核细胞增生李斯特氏菌传统分离培养基与显色培养基比较 | |
|---|---|
![]() | |
| PALCAM琼脂(李斯特氏菌传统分离培养基) 在此培养基上李斯特氏菌菌属的单增、英诺克、斯氏等均呈小的圆形灰绿色菌落,周围有棕黑色水解圈,无法区分。 | CRM013 单增李斯特氏菌显色培养基 在此培养基上单增/绵羊李斯特氏菌是蓝绿色菌落、英诺克/斯氏李斯特氏菌为无色菌落;属内不同种水平的菌落颜色对比清晰,易于区分。 |
其实,显色培养基在微生物检验领域已不是新鲜事物了,因为早在1979年它已出现在微生物领域中,至今有大约44年的发展史,在食品、临床、水质等微生物检验中的应用已经非常成熟了。近10年来,它逐步通过AOAC认可,并被引入FDA、ISO、GB等国内外官方微生物检验标准方法中,应用于大肠埃希氏菌、大肠菌群、单核细胞增生李斯特氏菌、克罗诺杆菌(阪崎肠杆菌)、沙门氏菌、志贺氏菌、副溶血性弧菌、大肠埃希菌O157 H7/NM检验。
国内外应用标准:
◆ 美国FDA(BAM) Chapter 10 April 2022 : Detection of Listeria monocytogenes in Foods and Environmental Samples, and Enumeration of Listeria monocytogenes in Foods
◆ 美国FDA(BAM) Chapter 29 02/28/2018 : Cronobacter
◆ ISO11290-1-2017 Microbiology of the food chain - Horizontal method for the detection and enumeration of Listeria monocytogenes and of Listeria spp. - Part 1: Detection method
◆ ISO 22964:2017 Microbiology of the food chain — Horizontal method for the detection of Cronobacter spp.
◆ ISO 9308-1:2014 Water quality - Enumeration of Escherichia coli and coliform bacteria - Part 1: Membrane filtration method for waters with low bacterial background flora
◆ ISO 16649-1-2018 Microbiology of the food chain. Horizontal method for the enumeration of beta-glucuron
◆ GB4789.4-2016 食品微生物学检验 沙门氏菌检验
◆ GB4789.5-2012 食品微生物学检验 志贺氏菌检验
◆ GB4789.7-2013 食品微生物学检验 副溶血性弧菌检验
◆ GB4789.30-2016 食品微生物学检验 单核细胞李斯特氏菌检验
◆ GB4789.36-2016 食品微生物学检验 大肠埃希菌O157 H7/NM检验
◆ GB4789.40-2016 食品微生物学检验 克罗诺杆菌属(阪崎肠杆菌)检验
环凯显色培养基图谱